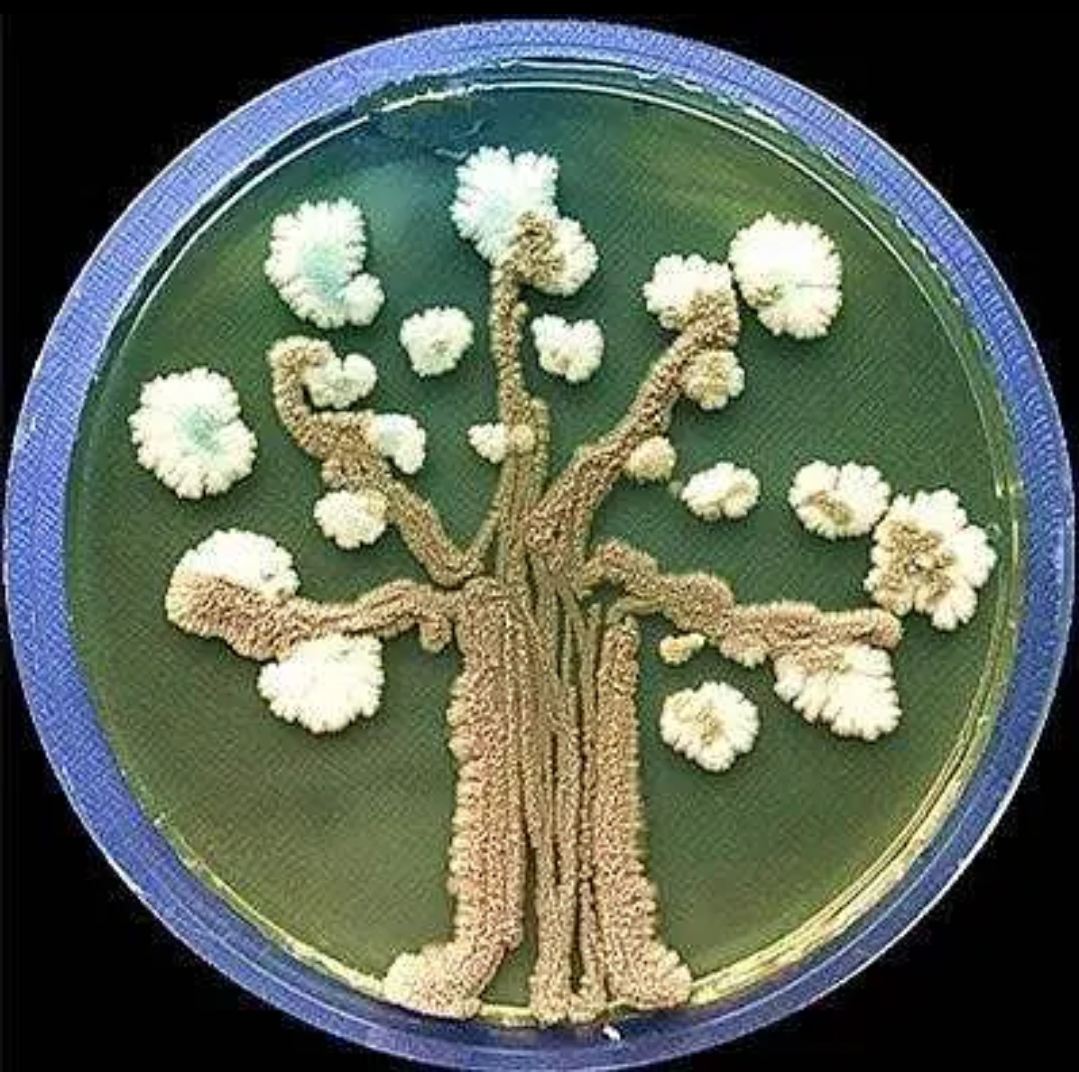
生物八下生物米勒实验(八年级下册生物米勒实验) 第2张 生物八下生物米勒实验(八年级下册生物米勒实验) 第2张

米勒实验没有开始和结束,实验本身是模拟的自然界的循环过程烧瓶底的水模拟的是海洋,煮水模拟的是海洋表面的水分蒸发产生大气中的水蒸气放电模拟雷电,冷却模拟的是自然界的降水例如降雨,冷凝后的水汇聚到烧瓶中的海洋中放电过程中产生的有机小分子会随着降水,汇集到烧瓶中的海洋里通过分析海洋。
此实验共生成20种有机物其中11种氨基酸中有4种即甘氨酸丙氨酸天冬氨酸和谷氨酸是生物的蛋白质所含有的以后,米勒认为,设想原始地球还原性大气的成分是CH4N2微量的NH3和H2O的混合气体更为合理,因为NH3不可能在大气中大量存在,它会溶于海水中他和他的合作者于1972年在上述混合气体中。
米勒实验的实验步骤及结果如下实验步骤1 装置准备实验装置包括一个500毫升的烧瓶和一个5升的大烧瓶烧瓶内注入水,并加入CH4NH3和H2的混合气体,以模拟早期地球的还原性大气2 反应条件在密闭的管道中,通过火花放电模拟雷鸣闪电,使水蒸气与混合气体在放电条件下发生反应3 产物收集。
在密闭的管道中,水蒸气与混合气体在火花放电模拟雷鸣闪电下反应,生成的有机物积聚在底部溶液中实验结果显示,总共产生了20种有机物,其中11种氨基酸中有4种甘氨酸丙氨酸天冬氨酸和谷氨酸是生物蛋白质的组成部分米勒的实验进一步证实了NH3在原始大气中可能存在的量较少,因为大部分会被。

米勒的实验展示了在早期地球条件下,无机物能够转化为小分子有机物的可能性这一实验模拟了早期地球上的大气环境和闪电现象,通过将水甲烷氨和氢气等无机物置于密闭容器中,并利用电火花模拟闪电,成功产生了氨基酸等小分子有机物该实验的意义不仅在于揭示了生命起源的一个关键步骤,还启发了科学家。
1米勒实验的结论为在一定的条件下,原始大气中各种成分能够转变为有机小分子物质,这个过程是生命起源的第一步2然而生命起源的第一步是从无机物形成有机小分子物质在原始地球的条件下是完全可以实现的3生命起源的学说有很多,其中化学起源说是被广大学者普遍接受的生命起源假说,化学起源说将生命。
米勒实验的结论主要包括以下几点在一定条件下,原始大气中的成分能够转变为有机小分子物质米勒实验通过模拟原始地球的大气环境,并施加能量如紫外线闪电等,成功地将原始大气中的无机成分如水蒸气甲烷氨氢气等转化为有机小分子物质,如氨基酸有机酸等这一发现证实了生命起源的第一。
米勒实验的结果表明,在特定的条件下,原始大气中的成分可以转化为有机小分子物质,这是生命起源的第一步生命起源的学说多种多样,其中化学起源说被普遍接受这一学说将生命的起源分为四个阶段首先是从无机小分子到有机小分子的转变接着是从有机小分子物质到生物大分子物质的生成然后是生物大分子物质组成多分子体系最后是有机多分子体。
三实验条件的局限性 需要注意的是,米勒实验虽然成功地模拟了原始地球的一部分环境,但并不能完全复现生命起源的全部条件因此,虽然实验验证了从无机小分子到有机小分子的转变过程,但生命起源的后续阶段,如从有机小分子到生物大分子再到多分子体系以及最终演变为原始生命的过程,仍然需要进一步的。
米勒实验也叫米勒尤里实验,是模拟在原始地球还原性大气中进行雷鸣闪电能产生有机物特别是氨基酸,以论证生命起源的化学进化过程的实验米勒尤里实验是 生命起源的经典实验之一,完成于1953年尤里和米勒在该实验装置中装上温水来模拟当时的海洋,引入了氢气甲烷和氨气,模拟早期大气层无氧气的。
米勒的实验说明,地球上现在的生物都是经过非常漫长的时间不断进化来的,生物进化的过程是复杂而漫长说明生命源于非生命物质,告诉我们要有严谨的科学求知态度勇于创新,就能有所发现 原始地球上尽管不能形成生命,但能形成构成生物体的有机物在原始地球的条件下,无机小分子转化为有机小分子是完全有。
第二阶段则是由有机小分子进一步合成生物大分子,为生命的构建奠定基础随后,第三阶段描述的是如何从生物大分子形成多分子体系,这标志着生命复杂结构的初步形成最后,第四阶段阐述有机多分子体系如何逐步演变为原始生命,标志着生命诞生的最终阶段米勒的实验特别验证了化学起源说的第一阶段,即无机物。
米勒的实验说明了什么原始大气成分能够转变为有机小分子 此实验结果共生成20种有机物其中11种氨基酸中有4种即甘氨酸丙氨酸天冬氨酸和谷氨酸是生物的蛋白质所含有的米勒的实验试图向人们证实,生命起源的第一步,从无机小分子物质形成有机小分子物质,在原始地球的条件下是完全可能实现的米勒。
这个过程可能涉及到非常基本的化学反应,而这些反应过程可以再现于早期类似地球的大气环境中这意味着生命的起源不仅是可能的,而且可能是在地球上自然发生的从生物学的角度来看,米勒实验表明了生命的基础化学组分可以在没有生命的情况下形成这个过程可能是通过非常基本的化学反应触发的这个结果意味着。
尽管历经多次重复和改进,它在中学生物教育中占据着重要地位,被频繁地用作考试题目该实验的关键在于模拟古大气的成分,如甲烷氨二氧化碳等,并再现高压特定温度和电闪雷鸣等条件米勒实验结果显示,溶液中出现了氨基酸等有机物,这表明在特定条件下,无机物可能转化为有机物然而,这并不直接。
接着,加热烧瓶内的水使之沸腾,产生水蒸气,这些气体在密闭的玻璃管道中不断循环为了模拟雷鸣闪电,实验还加入了火花放电装置经过一周的放电,最终生成了20种有机物,其中有4种氨基酸是生物蛋白质所含有的米勒后来认为,还原性大气成分应包括CH4N2微量NH3和H2O,NH3在大气中难以大量存在,会溶。


发表评论